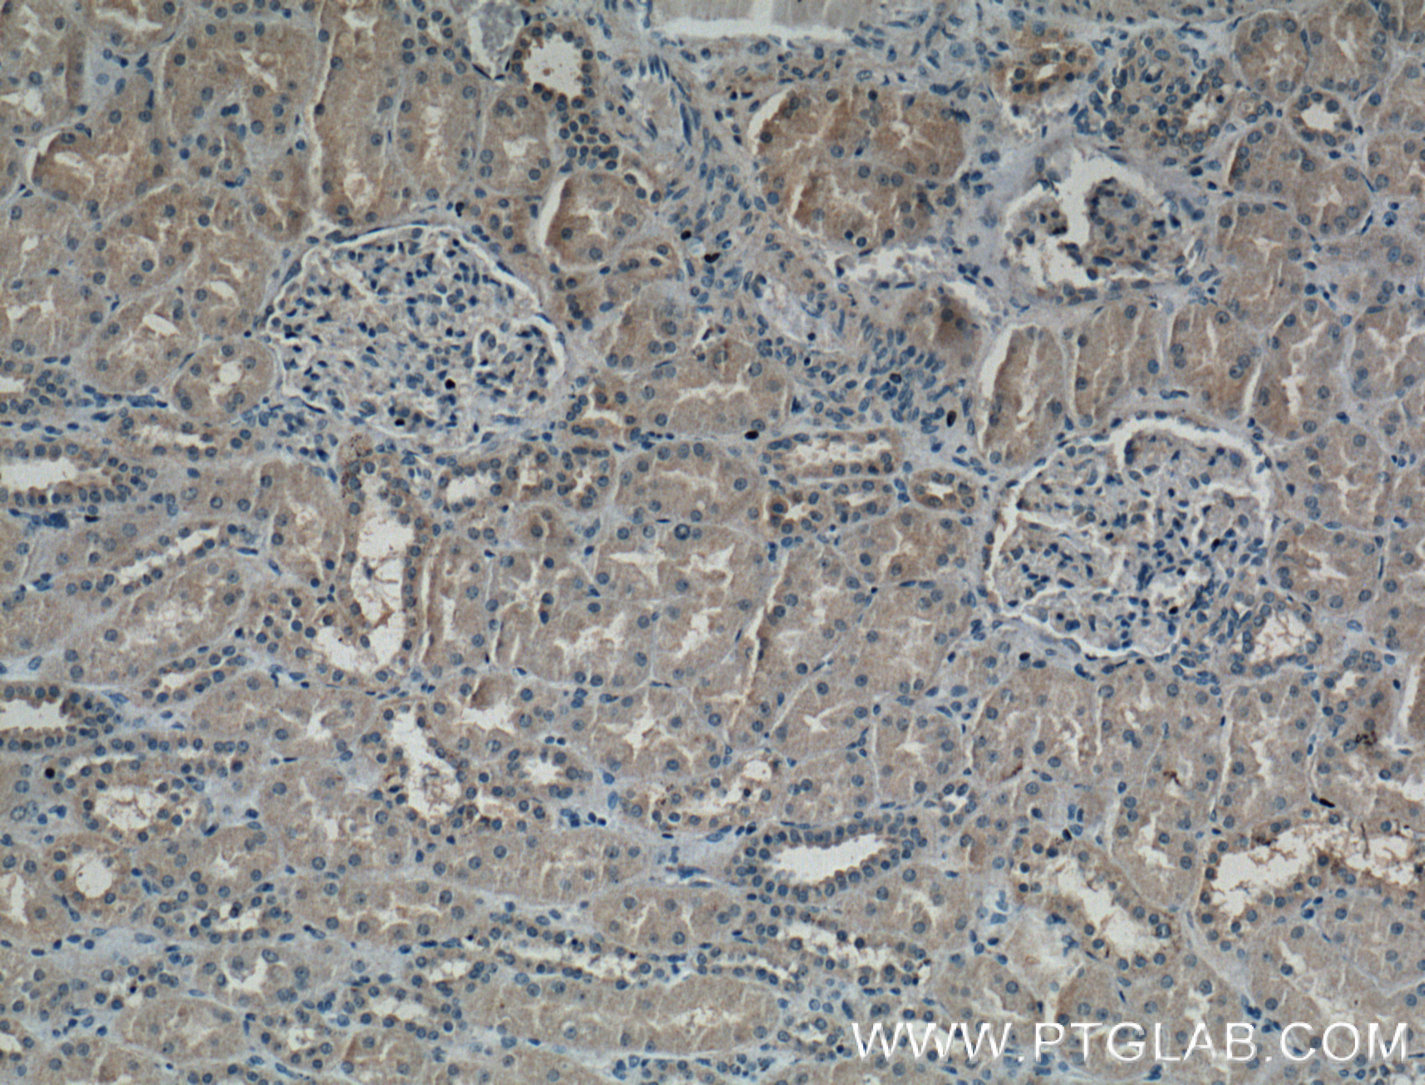

验证数据展示
经过测试的应用
| Positive WB detected in | human peripheral blood platelets, pig liver tissue, pig serum, HuH-7 cells, U-251 cells, SH-SY5Y cells |
| Positive IHC detected in | human kidney tissue, mouse lung tissue Note: suggested antigen retrieval with TE buffer pH 9.0; (*) Alternatively, antigen retrieval may be performed with citrate buffer pH 6.0 |
| Positive IF/ICC detected in | HepG2 cells |
推荐稀释比
| 应用 | 推荐稀释比 |
|---|---|
| Western Blot (WB) | WB : 1:5000-1:50000 |
| Immunohistochemistry (IHC) | IHC : 1:50-1:500 |
| Immunofluorescence (IF)/ICC | IF/ICC : 1:200-1:800 |
| It is recommended that this reagent should be titrated in each testing system to obtain optimal results. | |
| Sample-dependent, Check data in validation data gallery. | |
产品信息
66261-1-Ig targets Serpin E1/PAI-1 in WB, IHC, IF/ICC, ELISA applications and shows reactivity with human, mouse, pig samples.
| 经测试应用 | WB, IHC, IF/ICC, ELISA Application Description |
| 文献引用应用 | WB, IHC, IF |
| 经测试反应性 | human, mouse, pig |
| 文献引用反应性 | human, mouse, rat, pig |
| 免疫原 |
CatNo: Ag22411 Product name: Recombinant human SERPINE1 protein Source: e coli.-derived, PET28a Tag: 6*His Domain: 24-158 aa of BC010860 Sequence: VHHPPSYVAHLASDFGVRVFQQVAQASKDRNVVFSPYGVASVLAMLQLTTGGETQQQIQAAMGFKIDDKGMAPALRHLYKELMGPWNKDEISTTDAIFVQRDLKLVQGFMPHFFRLFRSTVKQVDFSEVERARFI 种属同源性预测 |
| 宿主/亚型 | Mouse / IgG1 |
| 抗体类别 | Monoclonal |
| 产品类型 | Antibody |
| 全称 | serpin peptidase inhibitor, clade E (nexin, plasminogen activator inhibitor type 1), member 1 |
| 别名 | PAI-1, SERPINE1, SERPINE1, PAI-1, 1H4A5, PAI |
| 计算分子量 | 402 aa, 45 kDa |
| 观测分子量 | 45-50 kDa |
| GenBank蛋白编号 | BC010860 |
| 基因名称 | PAI-1 |
| Gene ID (NCBI) | 5054 |
| RRID | AB_2881648 |
| 偶联类型 | Unconjugated |
| 形式 | Liquid |
| 纯化方式 | Protein G purification |
| UNIPROT ID | P05121 |
| 储存缓冲液 | PBS with 0.02% sodium azide and 50% glycerol, pH 7.3. |
| 储存条件 | Store at -20°C. Stable for one year after shipment. Aliquoting is unnecessary for -20oC storage. |
背景介绍
SERPINE1, also named Plasminogen activator inhibitor type 1 (PAI-1), is a member of the serine protease inhibitor (SERPIN) superfamily. PAI-1 is the principal inhibitor of tissue plasminogen activator (tPA) and uPA, and hence is an inhibitor of fibrinolysis. Defects in this gene are the cause of plasminogen activator inhibitor-1 deficiency (PAI-1 deficiency), and high concentrations of the gene product are associated with thrombophilia. The mature 379-residue protein had a calculated unglycosylated molecular mass of 42.7 kD. Three putative glycosylation sites were found.
实验方案
| Product Specific Protocols | |
|---|---|
| IF protocol for Serpin E1/PAI-1 antibody 66261-1-Ig | Download protocol |
| IHC protocol for Serpin E1/PAI-1 antibody 66261-1-Ig | Download protocol |
| WB protocol for Serpin E1/PAI-1 antibody 66261-1-Ig | Download protocol |
| Standard Protocols | |
|---|---|
| Click here to view our Standard Protocols |
发表文章
| Species | Application | Title |
|---|---|---|
Nat Aging Single-cell and spatial RNA sequencing identify divergent microenvironments and progression signatures in early- versus late-onset prostate cancer | ||
Front Immunol Immunological characterization of stroke-heart syndrome and identification of inflammatory therapeutic targets | ||
Int J Mol Sci Identification of Impacted Pathways and Transcriptomic Markers as Potential Mediators of Pulmonary Fibrosis in Transgenic Mice Expressing Human IGFBP5. | ||
Am J Respir Cell Mol Biol ZMPSTE24 Regulates SARS-CoV-2 Spike Protein-enhanced Expression of Endothelial Plasminogen Activator Inhibitor-1. | ||
Clin Sci (Lond) Anti-anemia drug FG4592 retards the AKI-to-CKD transition by improving vascular regeneration and antioxidative capability. | ||
Phytomedicine Rhamnocitrin extracted from Nervilia fordii inhibited vascular endothelial activation via miR-185/STIM-1/SOCE/NFATc3. |